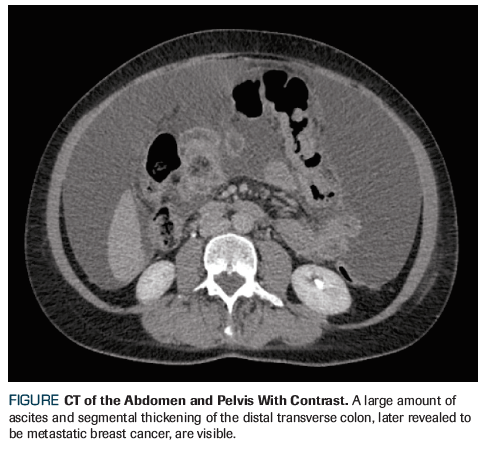

An otherwise healthy 58-year-old woman with a history of breast cancer presents to the clinic with newly diagnosed metastatic disease; eventual abdominal CT showed a mass in the transverse colon with ascites and peritoneal nodularity. What is the best initial systemic treatment for her?
Oncology (Williston Park). 32(10):513-5.

Jennifer Weiss, MD

Anosheh Afghahi, MD

Elena Shagisultanova, MD, PhD

Jennifer R. Diamond, MD

Figure. CT of the Abdomen and Pelvis With Contrast
An otherwise healthy 58-year-old woman with a history of breast cancer presents to the clinic with newly diagnosed metastatic disease. Nine years prior, she received a diagnosis of left-sided, stage IIIA (T2N2M0), grade 1 infiltrating lobular carcinoma (ILC). She was premenopausal at the time. Her original breast biopsy revealed ILC, with estrogen receptor (ER) positivity (44%), progesterone receptor (PR) negativity, and human epidermal growth factor receptor 2 (HER2) negativity by fluorescence in situ hybridization (FISH). Left mastectomy was completed, and an axillary lymph node dissection showed a 4.0-cm tumor and 6/12 positive axillary nodes. Postoperative staging with PET/CT showed no evidence of distant metastatic disease. She completed 6 cycles of adjuvant docetaxel, doxorubicin, and cyclophosphamide chemotherapy followed by postmastectomy chest wall and regional nodal radiation, and was started on tamoxifen. A contralateral risk-reducing mastectomy and bilateral salpingo-oophorectomy were completed about 1 year after diagnosis. The patient stopped her adjuvant tamoxifen after approximately 1 year due to side effects and loss of health insurance.
Recently, the patient developed increasing abdominal pain, bloating, and constipation with smaller-caliber stools. Abdominal CT showed a mass in the transverse colon with ascites and peritoneal nodularity (Figure). No obvious liver metastasis or cirrhosis were present. Colonoscopy was attempted, but the stricture resulting from the colon mass was unable to be traversed. A palliative exploratory laparotomy with subtotal colectomy was performed due to impending complete obstruction. The pathology report revealed infiltration of poorly differentiated carcinoma-most consistent with breast primary-in the sampled small intestine, large intestine, appendix, and mesentery. Margins were positive. Immunologic stains were positive for mammaglobin, GATA binding protein 3 (GATA-3), and cytokeratin 7 (CK7). The sample was positive for ER (3+, 90%) and PR (3+, 5%) but negative for HER2. Following surgery, the patient’s normal bowel function returned, and she was referred to oncology for treatment of her newly diagnosed metastatic breast cancer.
Which of the following represents the best initial systemic treatment for this patient?A. Letrozole + palbociclib
B. Letrozole alone
C. Fulvestrant + abemaciclib
D. Capecitabine
Correct Answer: A. Letrozole and palbociclib
This case involves a postmenopausal woman with a history of ILC who has newly diagnosed ER/PR-positive, HER2-negative metastatic breast cancer, with disease that has spread to the gastrointestinal tract. She is presenting for initial systemic therapy.
Breast cancer is the most common cancer diagnosed in women in the United States; about 60% to 70% of cases are hormone receptor (HR) positive.[1] While infiltrating ductal carcinoma (IDC) is the dominant histologic breast cancer subtype, ILC represents about 10% to 15% of cases.[2] As illustrated in this case, ILC has unique patterns of potential metastatic recurrence with more frequent involvement of the gastrointestinal tract, gynecologic organs, and peritoneum compared to IDC.[3] Systemic treatment of ILC does not differ from that of IDC at present, and therapy in the metastatic setting should be based on the patient’s HR and HER2 status.
The preferred first-line treatment of metastatic HR-positive, HER2-negative breast cancer is endocrine therapy, unless the patient has impending visceral crisis.[4,5] For postmenopausal women with no prior endocrine therapy and metastatic disease, the current National Comprehensive Cancer Network (NCCN) guidelines recommend either an aromatase inhibitor (AI) such as anastrozole; tamoxifen, a selective ER modulator; fulvestrant, a selective ER downregulator; or a combination of a cyclin-dependent kinase (CDK) 4/6 inhibitor with an aromatase inhibitor.
If single-agent endocrine therapy is desired, an AI or fulvestrant is preferred over tamoxifen based on reduced time to progression.[6,7] The FALCON trial compared fulvestrant vs the nonsteroidal AI (NSAI) anastrozole in patients with HR-positive, HER2-negative advanced breast cancer in the first-line setting. Progression-free survival (PFS) was significantly improved in the fulvestrant arm compared with the anastrozole arm, further supporting the use of fulvestrant (16.6 months vs 13.8 months; hazard ratio [HR], 0.797; 95% CI, 0.637–0.999; P = .0486).[8]
While single-agent endocrine therapy remains an option for some patients, adding CDK4/6 inhibitors to NSAIs markedly increases the PFS in patients with metastatic HR-positive, HER2-negative breast cancer in the first-line setting.[9] The CDK4/6-cyclin D-retinoblastoma (RB) pathway functions as a critical checkpoint for cell cycle progression and is particularly active in HR-positive breast cancer.[10] CDK 4 and 6 bind to D-type cyclins to form an active complex, which phosphorylates the RB protein, resulting in the release of the E2F transcription factor. This leads to cellular transition from G1 (pre-DNA synthesis) to the S (DNA synthesis) phase of the cell cycle, allowing cell cycle progression.[11] Cyclin D is a transcriptional target of the ER and can be upregulated by ER signaling and the MAPK-ERK and PI3K-AKT signaling pathways.[12] In HR-positive breast cancer, RB function is generally retained, making CDK4/6 inhibition effective at stopping cell cycle progression.[13]
In the first-line setting, three CDK4/6 inhibitors-palbociclib, ribociclib, and abemaciclib-are all approved by the US Food and Drug Administration (FDA) in combination with NSAIs based on the results of the phase III PALOMA-2, MONALEESA-2, and MONARCH-3 trials, respectively. PALOMA-2 was a double-blind randomized clinical trial that enrolled 666 postmenopausal patients with HR-positive, HER2-negative advanced breast cancer. Patients were randomized to letrozole plus palbociclib or letrozole plus placebo; the primary endpoint was PFS. Significant improvement in median PFS was seen at 14.4 months with letrozole-placebo and at 24.8 months with letrozole-palbociclib (HR, 0.58; 95% CI, 0.46–0.72; P < .001).[14] Improved PFS was seen in all subgroups, including those with visceral metastasis (HR, 0.63) and lobular carcinoma (HR, 0.46), which is relevant to this case. Overall survival data are not yet available for PALOMA-2, MONALEESA-2, or MONARCH-3.
The MONALEESA-2 trial also enrolled patients with HR-positive, HER2-negative advanced breast cancer without prior systemic treatment for metastatic disease. Participants were randomized to letrozole plus ribociclib or letrozole plus placebo.[15] As with the PALOMA-2 trial, this study also found an increase in the primary endpoint of PFS in the letrozole plus ribociclib arm compared with the letrozole plus placebo arm (25.3 months vs 16.0 months; HR, 0.568; 95% CI, 0.457–0.704; P = 9.63 × 10-8).[16] No subgroup analysis was available for patients with ILC. In MONARCH-3, patients were randomized to abemaciclib or placebo plus either anastrozole or letrozole.[17] PFS was significantly longer in the abemaciclib-NSAI arm compared with the NSAI-alone arm (HR, 0.540; 95% CI, 0.418–0.698; P < .0001). Follow-up analysis found median PFS to be 14.8 months and 28.2 months for the placebo-NSAI arm and the abemaciclib-NSAI arm, respectively.[18]
Beyond their first-line indications, palbociclib, ribociclib, and abemaciclib are all FDA-approved in combination with fulvestrant as second-line therapy based on significant improvements in PFS seen in the PALOMA-3, MONALEESA-3, and MONARCH-2 trials.[19-21] Additionally, the MONALEESA-3 trial included patients with up to one prior line of endocrine therapy in the advanced setting and led to the recent approval of ribociclib and fulvestrant in the first-line setting. Data also support the use of CDK4/6 inhibitors in premenopausal women. Namely, the MONALEESA-7 trial showed an increased PFS in premenopausal women with advanced HR-positive breast cancer with ribociclib plus goserelin and either tamoxifen or a NSAI.[22] Finally, abemaciclib is unique in its single-agent activity in heavily pretreated patients and in those with brain metastasis.[23,24]
In summary, palbociclib, ribociclib, and abemaciclib all significantly prolong PFS when added to an NSAI in the first-line setting. Overall survival data are not yet available, and extensive subset analysis has not revealed a predictor of response beyond HR positivity.[25] Response rates are high for combination therapy with a CDK4/6 inhibitor, and this treatment may be considered in patients with symptomatic visceral disease.
The decision on which CDK4/6 inhibitor to use for an individual patient should be based on the unique features of these agents, including their side effect profiles. The most common dose-limiting toxicity seen with palbociclib and ribociclib is neutropenia. In the PALOMA-2 trial, 66.4% of patients on palbociclib developed grade 3 or 4 neutropenia compared with 1.4% of patients in the placebo group.[14] Febrile neutropenia was uncommon. Administration of palbociclib or ribociclib requires complete blood count monitoring, and dose modifications may be necessary. QT interval prolongation has been reported with ribociclib (3.3% of patients in MONALEESA-2), and electrocardiography monitoring is recommended. Abemaciclib results in less neutropenia, with only 21.1% of patients having grade 3 or 4 neutropenia compared with 1.2% of patients taking placebo in the MONARCH-3 trial.[17] Diarrhea is the most common dose-limiting toxicity of abemaciclib: 81.3% of patients developed diarrhea compared with 29.8% of those taking placebo. However, most experienced grade 1 (44.6%) or grade 2 diarrhea (27.2%), while only 9.5% experienced grade 3 and no patients experienced grade 4. Increased thromboembolic events have also been observed with abemaciclib (4.9% vs 0.6% with placebo).
Based on these new trials, letrozole and palbociclib (Answer A) is the recommended first-line treatment for this patient with postmenopausal, HR-positive, HER2-negative metastatic breast cancer rather than endocrine therapy alone (Answer B). Specifically, the PALOMA-2 trial, including the lobular carcinoma and visceral metastasis subgroup analysis, demonstrated increased PFS with letrozole and palbociclib. Given the patient’s recent colectomy, the side effect profile of palbociclib is more desirable than that of abemaciclib, which includes increased risk of severe diarrhea. Combination therapy with ribociclib and letrozole is another reasonable option for our patient. Currently, fulvestrant and abemaciclib (Answer C) is approved only as second- or third-line therapy based on the results of the PALOMA-3 trial discussed previously, making this answer choice incorrect. Chemotherapy, such as capecitabine (Answer D), is not recommended for first-line treatment of metastatic HR-positive breast cancer, since the patient is not in visceral crisis.
The patient was started on letrozole and palbociclib for initial treatment of her HR-positive, HER2-negative metastatic breast cancer. She is still receiving treatment and is being monitored for disease progression.
Financial Disclosure: The authors have no significant financial interest in or other relationship with the manufacturer of any product or provider of any service mentioned in this article.
1. Matutino A, Joy AA, Brezden-Masley C, et al. Hormone receptor-positive, HER2-negative metastatic breast cancer: redrawing the lines. Curr Oncol. 2018;25(suppl 1):S131-41.
2. Yoder BJ, Wilkinson EJ, Massoll NA. Molecular and morphologic distinctions between infiltrating ductal and lobular carcinoma of the breast. Breast J. 2007;13:172-9.
3. Borst MJ, Ingold JA. Metastatic patterns of invasive lobular versus invasive ductal carcinoma of the breast. Surgery. 1993;114:637-41; discussion 641-2.
4. National Comprehensive Cancer Network. NCCN clinical practice guidelines in oncology: breast cancer, version 1. https://www.nccn.org/professionals/physician_gls/pdf/breast.pdf. Accessed September 7, 2018.
5. Wilcken N, Hornbuckle J, Ghersi D. Chemotherapy alone versus endocrine therapy alone for metastatic breast cancer. Cochrane Database Syst Rev. 2003;2:CD002747.
6. Nabholtz JM, Buzdar A, Pollak M, et al. Anastrozole is superior to tamoxifen as first-line therapy for advanced breast cancer in postmenopausal women: results of a North American multicenter randomized trial. Arimidex Study Group. J Clin Oncol. 2000;18:3758-67.
7. Gibson L, Lawrence D, Dawson C, Bliss J. Aromatase inhibitors for treatment of advanced breast cancer in postmenopausal women. Cochrane Database Syst Rev. 2009;4:CD003370.
8. Robertson JFR, Bondarenko IM, Trishkina E, et al. Fulvestrant 500 mg versus anastrozole 1 mg for hormone receptor-positive advanced breast cancer (FALCON): an international, randomised, double-blind, phase 3 trial. Lancet. 2016;388:2997-3005.
9. Messina C, Cattrini C, Buzzatti G, et al. CDK4/6 inhibitors in advanced hormone receptor-positive/HER2-negative breast cancer: a systematic review and meta-analysis of randomized trials. Breast Cancer Res Treat. 2018 Jul 27. [Epub ahead of print]
10. Tripathy D, Bardia A, Sellers WR. Ribociclib (LEE011): Mechanism of action and clinical impact of this selective cyclin-dependent kinase 4/6 inhibitor in various solid tumors. Clin Cancer Res. 2017;23:3251-62.
11. Ingham M, Schwartz GK. Cell-cycle therapeutics come of age. J Clin Oncol. 2017;35:2949-59.
12. Lim JS, Turner NC, Yap TA. CDK4/6 inhibitors: promising opportunities beyond breast cancer. Cancer Discov. 2016;6:697-9.
13. Pernas S, Tolaney SM, Winer EP, Goel S. CDK4/6 inhibition in breast cancer: current practice and future directions. Ther Adv Med Oncol. 2018;10:1758835918786451.
14. Finn RS, Martin M, Rugo HS, et al. Palbociclib and letrozole in advanced breast cancer. N Engl J Med. 2016;375:1925-36.
15. Hortobagyi GN, Stemmer SM, Burris HA, et al. Ribociclib as first-line therapy for HR-positive, advanced breast cancer. N Engl J Med. 2016;375:1738-48.
16. Hortobagyi GN, Stemmer SM, Burris HA, et al. Updated results from MONALEESA-2, a phase III trial of first-line ribociclib plus letrozole versus placebo plus letrozole in hormone receptor-positive, HER2-negative advanced breast cancer. Ann Oncol. 2018;29:1541-7.
17. Goetz MP, Toi M, Campone M, et al. MONARCH 3: abemaciclib as initial therapy for advanced breast cancer. J Clin Oncol. 2017;35:3638-46.
18. US Food and Drug Administration; Drugs@FDA. VERZENIOTM (abemaciclib) tablets label. https://www.accessdata.fda.gov/drugsatfda_docs/label/2018/208855s000lbl.pdf. Accessed September 7, 2018.
19. Turner NC, Ro J, André F, et al; PALOMA3 Study Group. Palbociclib in hormone-receptor-positive advanced breast cancer. N Engl J Med. 2015;373:209-19.
20. Slamon DJ, Neven P, Chia S, et al. Phase III randomized study of ribociclib and fulvestrant in hormone receptor-positive, human epidermal growth factor receptor 2-negative advanced breast cancer: MONALEESA-3. J Clin Oncol. 2018;36:2465-72.
21. Sledge GW Jr, Toi M, Neven P, et al. MONARCH 2: abemaciclib in combination with fulvestrant in women with HR+/HER2- advanced breast cancer who had progressed while receiving endocrine therapy. J Clin Oncol. 2017;35:2875-84.
22. Tripathy D, Im SA, Colleoni M, et al. Ribociclib plus endocrine therapy for premenopausal women with hormone-receptor-positive, advanced breast cancer (MONALEESA-7): a randomised phase 3 trial. Lancet Oncol. 2018;19:904-15.
23. Dickler MN, Tolaney SM, Rugo HS, et al. MONARCH 1: a phase II study of abemaciclib, a CDK4 and CDK6 inhibitor, as a single agent, in patients with refractory HR+/HER2- metastatic breast cancer. Clin Cancer Res. 2017;23:5218-24.
24. Tolaney SM, Lin NU, Thornton D, et al. Abemaciclib for the treatment of brain metastases (BM) secondary to hormone receptor positive (HR+), HER2 negative breast cancer. J Clin Oncol. 2017;35(suppl):abstr 1019.
25. Finn R, Jiang Y, Rugo H, et al. Biomarker analyses from the phase 3 PALOMA-2 trial of palbociclib (P) with letrozole (L) compared with placebo (PLB) plus L in postmenopausal women with ER+/HER2– advanced breast cancer (ABC). Ann Oncol. 2016;27(suppl 6):abstr LBA15.
26. Finn RS, Martin M, Rugo HS, et al. Palbociclib and Letrozole in Advanced Breast Cancer. N Engl J Med. 2016;375:1925-36.
27. Baselga J, Campone M, Piccart M, et al. Everolimus in postmenopausal hormone-receptor-positive advanced breast cancer. N Engl J Med. 2012;366:520-9.
Late Hepatic Recurrence From Granulosa Cell Tumor: A Case Report
Granulosa cell tumors exhibit late recurrence and rare hepatic metastasis, emphasizing the need for lifelong surveillance in affected patients.